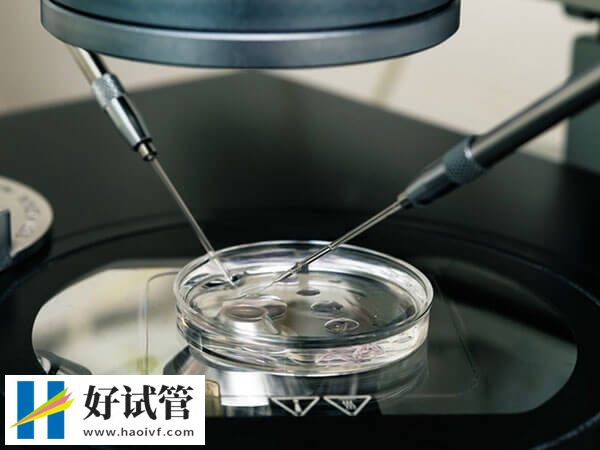
探秘重庆市妇幼保健院人工受孕,附项目收费情况及着床率(图1) 重庆市妇幼保健院试管贵不贵

探秘重庆市妇幼保健院人工受孕,附项目收费情况及着床率
重庆市妇幼保健院(重庆市妇产科医院、重庆市遗传与生殖研究所)下设冉家坝院区和七星岗院区两个院区。冉家坝院区位于重庆市渝北区龙山路120号,七星岗院区位于重庆市渝中区金塘街64号,始建于1944年,是一所集医疗、妇幼保健、科研、教学为一体的三级甲等妇幼保健院。每年前来就医的不孕症患者是络绎不绝,通过试管技术达成生育愿望的家庭不在少数,有部分特殊要求的患者就想了解该医院做试管的费用需要多少?为此,特整理出了重庆市妇幼保健院做试管最新费用明细及成功率,供大家参考。
重庆市妇幼保健院试管婴儿费用明细
在重庆市妇幼保健院做试管大概需要4万左右,具体费用不太确定,主要受医院级别、患者身体状况、治疗方案等等影响,如果女性子宫环境不好,需要药物调理,或者药物又不能很好的吸收,而且用药时间长,试管费用也会无形增加,因此就导致了有的患者花费少,有的患者花费多,不过重庆市妇幼保健院的试管技术挺好的,详细的费用明细如下:
体检费用
一般患者夫妻需要进行一系列的体检,包括精液、卵子、生殖器官的检查,此外还需要进行全面的身体检查,以确保身体状况符合进行试管婴儿的要求。费用在3000-7000元左右。

药品费用
试管婴儿需要使用一系列的药物来促进卵子的发育和排卵,还需要使用促性腺激素等药物来促进卵子和精子的结合。这些药品都是比较昂贵的,这部分价格在1-2万左右。
手术费用
试管婴儿手术的费用包括卵子采集、精子提取等环节,另外,试管婴儿手术后需要进行一系列的检查和治疗,以确保胚胎的安全和健康,费用在8000-15000元左右。
重庆市妇幼保健院试管成功率
重庆妇幼试管婴儿成功率普遍在50%到60%左右,处于国内的超前水平。重庆妇幼保健院是西部首例“试管婴儿”诞生地,这家医院目前可以开展的试管婴儿技术是比较全面的,一、二、三代都能够正式的开展,可以解决很多夫妻的生育需求。重庆妇幼保健院近几年的住院服务量4.29万人次,分娩量16954人次(居重庆市首1位),试管婴儿移植周期17021例(居西部地区首一位),这也是重庆妇幼保健院的试管婴儿成功率比较高的原因。不过决定试管婴儿成功率的因素有很多,不光有医院的水平、医生的技术,还包括了夫妻身体状态、胚胎质量、子宫内膜接受性、心理因素等等。





